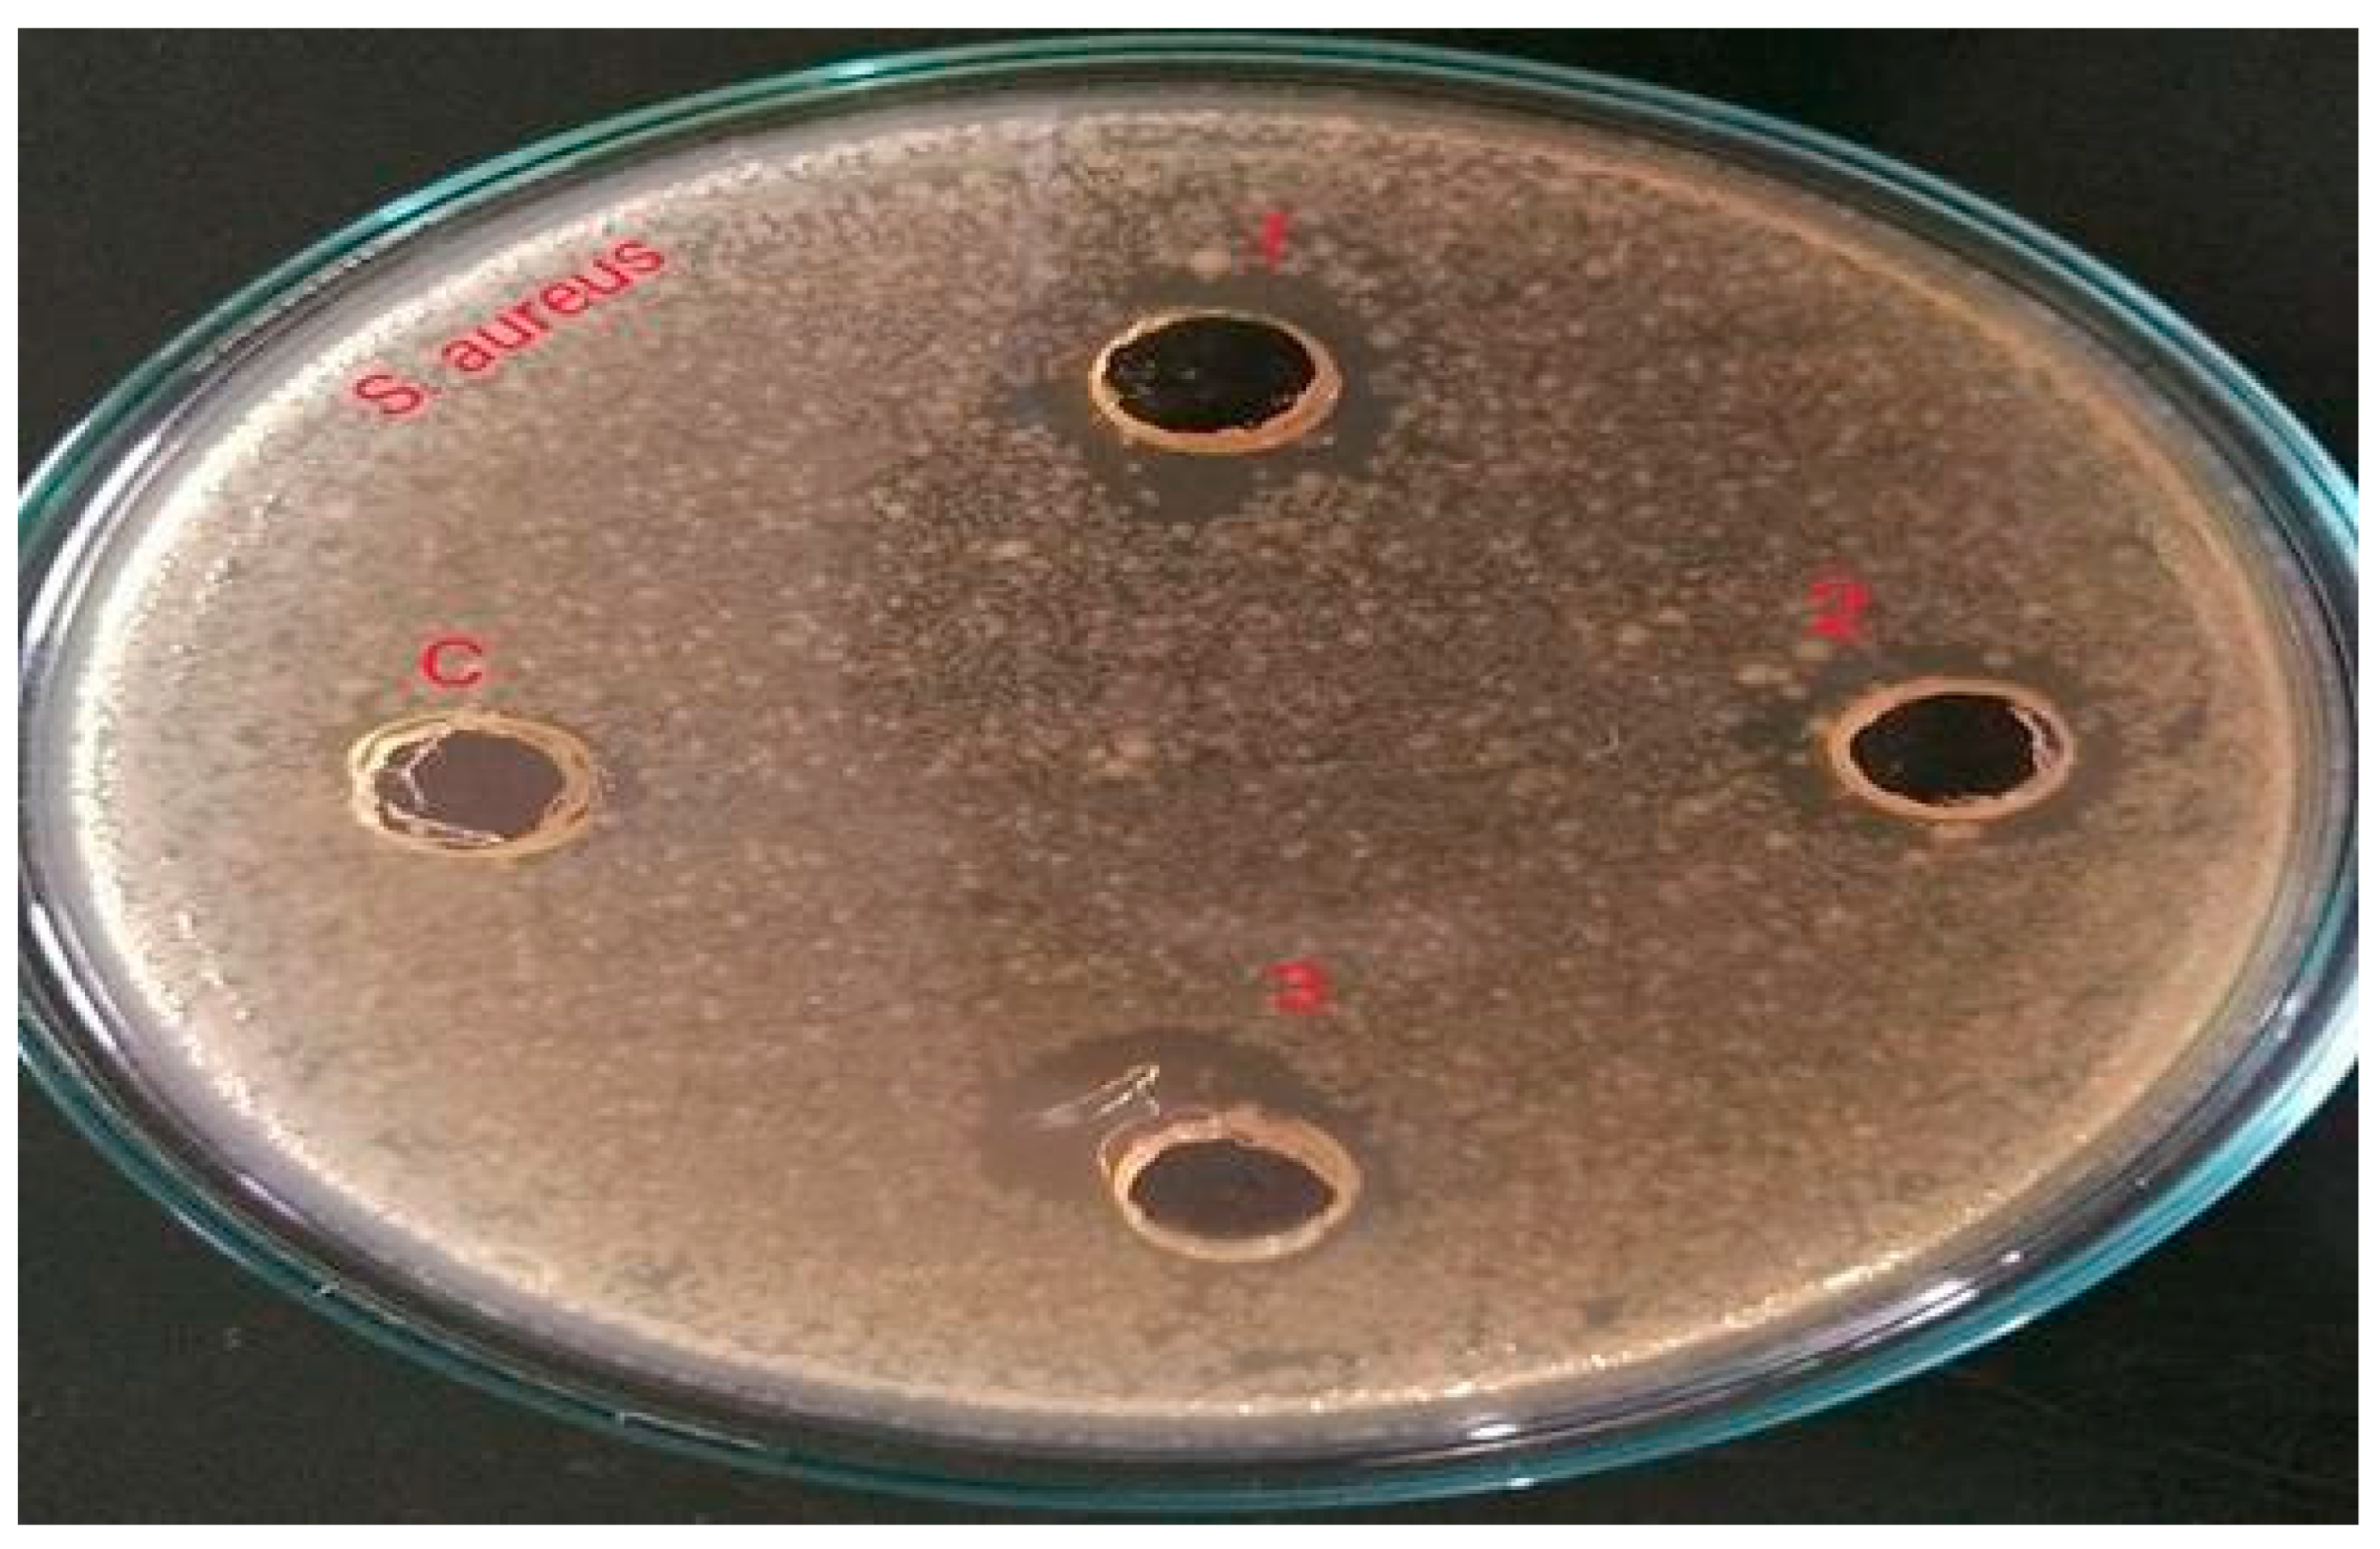
Gels 09 00163 g001
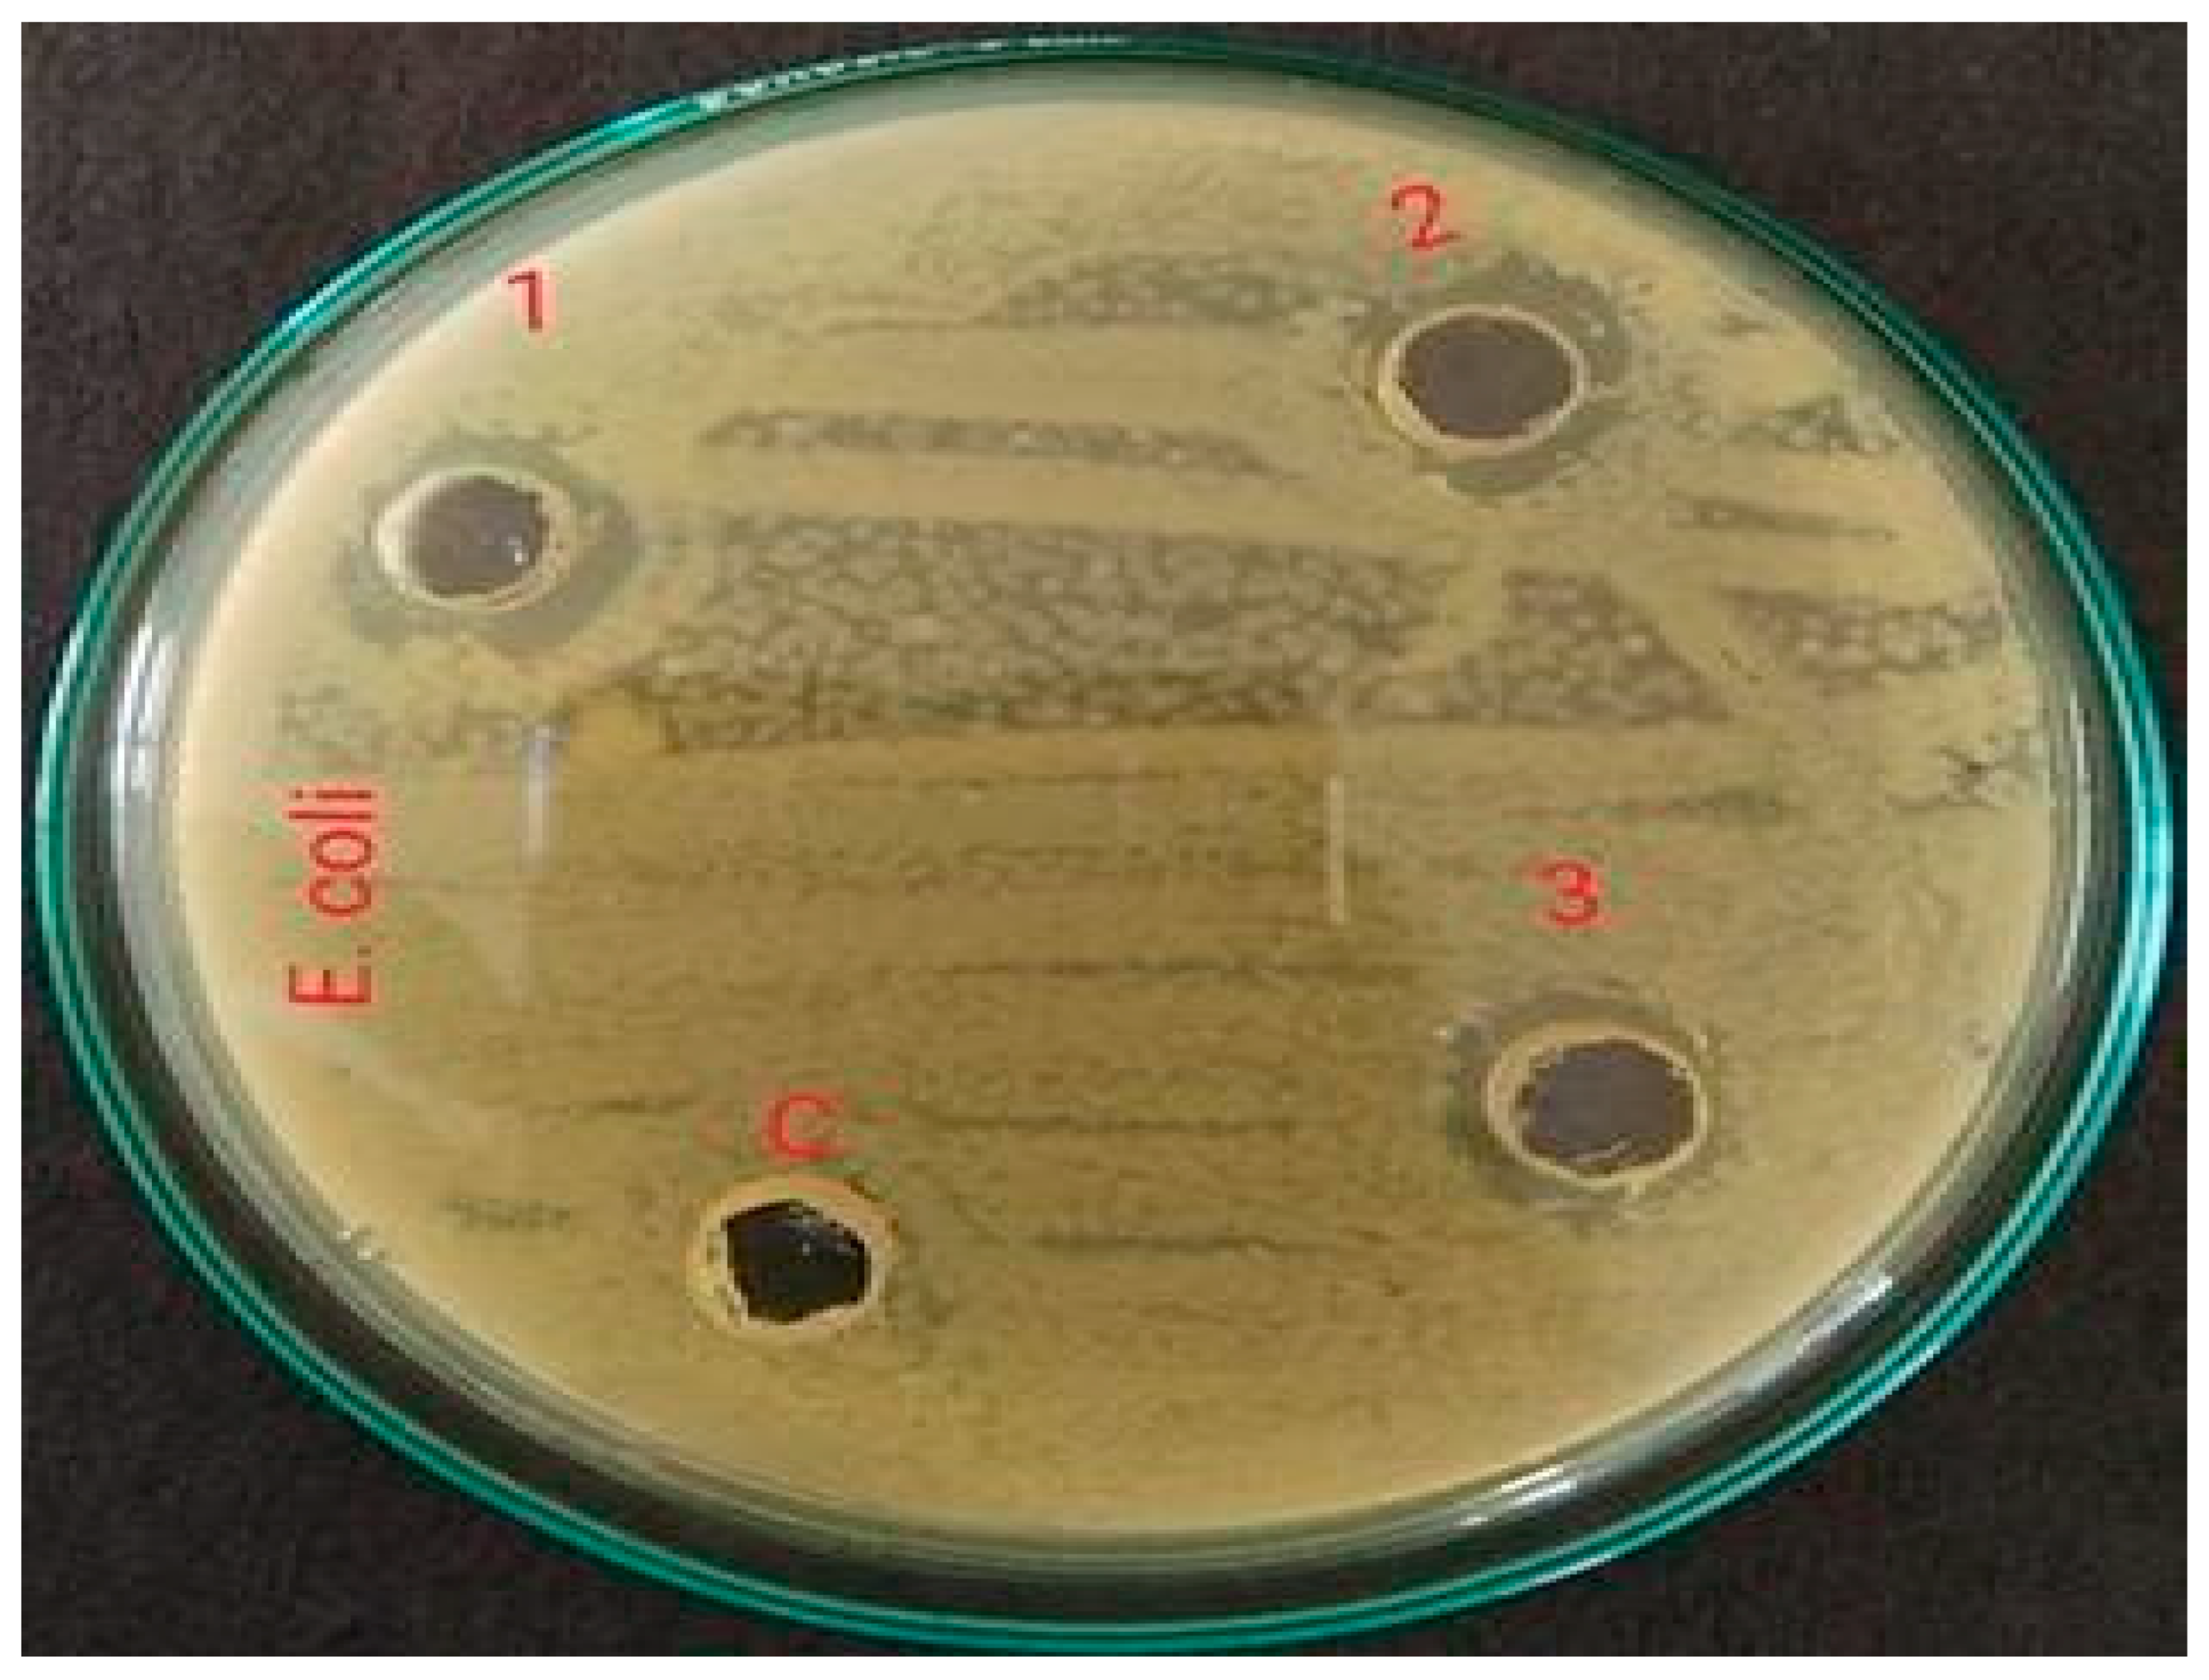
Gels 09 00163 g002
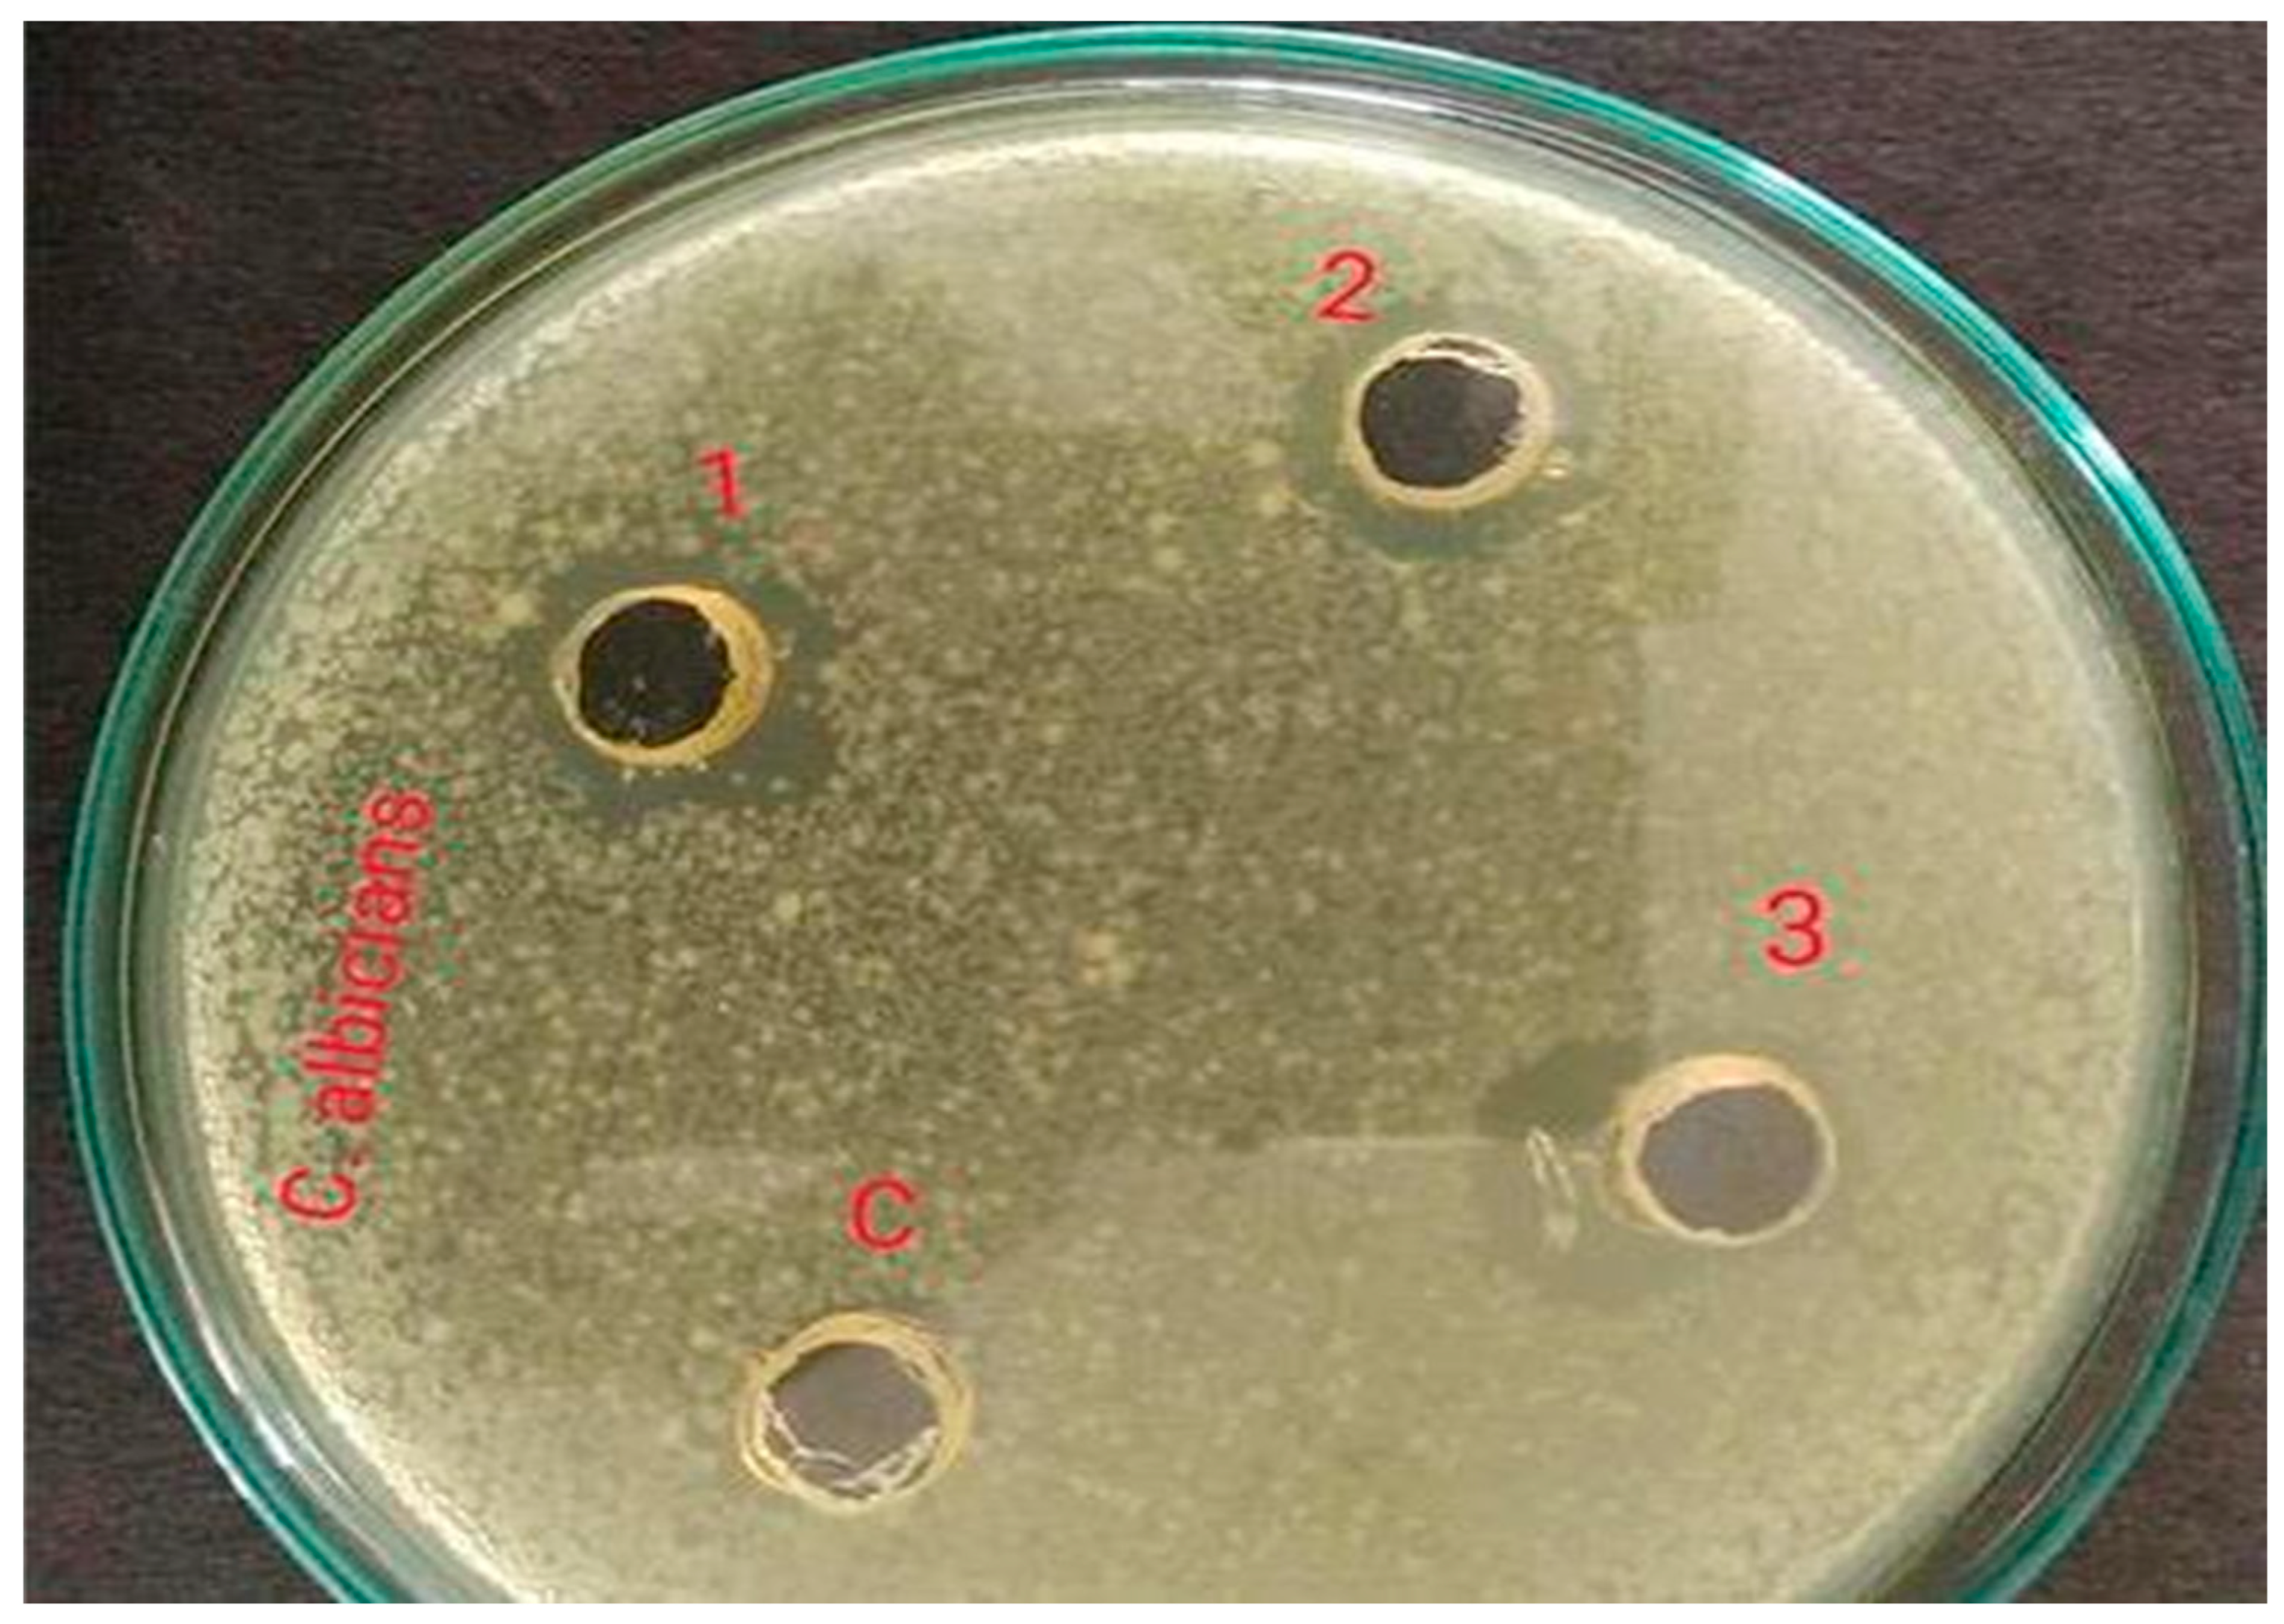
Gels 09 00163 g003

Development of a Polyherbal Topical Gel for the Treatment of Acne
Abstract
1. Introduction
2. Results and Discussion
2.1. Organoleptic Evaluation of the Extract of Vigna radiata
2.2. Phytochemical Investigation of the Extract
2.3. Antimicrobial Activity of the Extract
2.4. Optimization of Gelling Agent
2.5. Formulation of Polyherbal Gel Containing Vigna radiata and Aloe barbadensis
2.6. Evaluation of Polyherbal Gel Physical Appearance
2.7. pH Determination
2.8. Determination of Viscosity
2.9. Spreadability
2.10. Gel Strength Analysis
2.11. Extrudability
3. Conclusions
4. Materials and Methods
4.1. Materials
4.2. Methods
4.2.1. Extraction of Vigna radiata
4.2.2. Collection of Aloe barbadensis Gel
4.2.3. Evaluation of the Vigna radiata Extract
Characteristics of Extract
Phytochemical Investigation of the Extract
Determination of Anti-Infective Activity
4.2.4. Standardization of Inoculum
4.2.5. Antimicrobial Activity by Cup Plate Method
4.2.6. Formulation of Gel Base and Optimization
4.2.7. Formulation of Polyherbal Gel Containing Vigna radiata and Aloe barbadensis
4.2.8. Physical Characterization of the Formulated Acne Gel
4.2.9. Physical Appearance
4.2.10. Determination of pH
4.2.11. Determination of Viscosity
4.2.12. Spreadability
4.2.13. Analysis of Gel Strength and Extrudability
Supplementary Materials
Author Contributions
Funding
Institutional Review Board Statement
Informed Consent Statement
Data Availability Statement
Acknowledgments
Conflicts of Interest
References
- Lee, W.Y.; Lee, C.Y.; Kim, Y.S.; Kim, C.E. The methodological trends of traditional herbal medicine employing network pharmacology. Biomolecules 2019, 9, 362. [Google Scholar] [CrossRef] [PubMed]
- Balkrishna, A.; Bhatt, A.B.; Singh, P.; Haldar, S.; Varshney, A. Comparative retrospective open-label study of ayurvedic medicines and their combination with allopathic drugs on asymptomatic and mildly-symptomatic COVID-19 patients. J. Herb. Med. 2021, 29, 100472. [Google Scholar] [CrossRef] [PubMed]
- Folle, C.; Díaz-Garrido, N.; Sánchez-López, E.; Marqués, A.M.; Badia, J.; Baldomà, L.; Espina, M.; Calpena, A.C.; García, M.L. Surface-modified multifunctional thymol-loaded biodegradable nanoparticles for topical acne treatment. Pharmaceutics 2021, 13, 1501. [Google Scholar] [CrossRef] [PubMed]
- Scomoroscenco, C.; Teodorescu, M.; Raducan, A.; Stan, M.; Voicu, S.N.; Trica, B.; Ninciuleanu, C.M.; Nistor, C.L.; Mihaescu, C.I.; Petcu, C.; et al. Novel gel microemulsion as topical drug delivery system for curcumin in dermatocosmetics. Pharmaceutics 2021, 13, 505. [Google Scholar] [CrossRef]
- Boomi, P.; Ganesan, R.; Prabu Poorani, G.; Jegatheeswaran, S.; Balakumar, C.; Gurumallesh Prabu, H.; Anand, K.; Marimuthu Prabhu, N.; Jeyakanthan, J.; Saravanan, M. Phyto-engineered gold nanoparticles (AuNPs) with potential antibacterial, antioxidant, and wound healing activities under in vitro and in vivo conditions. Int. J. Nanomed. 2020, 15, 7553–7568. [Google Scholar] [CrossRef]
- Masoud, F.; Badali, P.; Isa, M.A.; Alamdari, H.A.; Asnaashari, S.; Shokri, J.; Javadzadeh, Y. The novel topical herbal gel might be an alternative treatment in patients with acne vulgaris: A randomized, double-blind controlled study. Phytomed. Plus 2022, 2, 100232. [Google Scholar] [CrossRef]
- Marji, S.M.; Bayan, M.F.; Jaradat, A. Facile fabrication of methyl gallate encapsulated folate ZIF-L nanoframeworks as a pH responsive drug delivery system for anti-biofilm and anticancer therapy. Biomimetics 2022, 7, 242. [Google Scholar] [CrossRef]
- Ahmadian, E.; Eftekhari, A.; Kavetskyy, T.; Khosroushahi, A.Y.; Turksoy, V.A.; Khalilov, R. Effects of quercetin loaded nanostructured lipid carriers on the paraquat-induced toxicity in human lymphocytes. Pestic. Biochem. Physiol. 2020, 167, 104586. [Google Scholar] [CrossRef]
- Hasanzadeh, A.; Gholipour, B.; Rostamnia, S.; Eftekhari, A.; Tanomand, A.; Valizadeh AKhaksar, K.S.; Khalilov, R. Biosynthesis of AgNPs onto the urea-based periodic mesoporous organosilica (AgxNPs/Ur-PMO) for antibacterial and cell viability assay. J. Colloid Interface Sci. 2021, 585, 676–683. [Google Scholar] [CrossRef]
- Ahmadian, E.; Khosroushahi, A.Y.; Eftekhari, A.; Farajnia, S.; Babaei, H.; Eghbal, M.A. Novel angiotensin receptor blocker, azilsa tan induces oxidative stress and NFkB-mediated apoptosis in hepatocellular carcinoma cell line HepG2. Biomed. Pharmacother. 2018, 99, 939–946. [Google Scholar] [CrossRef]
- Oon, H.H.; Wong, S.N.; Aw, D.C.; Cheong, W.K.; Goh, C.L.; Tan, H.H. Acne management guidelines by the dermatological society of Singapore. J. Clin. Aesthetic Dermatol. 2019, 12, 34. [Google Scholar]
- Asthana, N.; Pal, K.; Aljabali, A.A.; Tambuwala, M.M.; de Souza, F.G.; Pandey, K. Polyvinyl alcohol (PVA) mixed green–clay and aloe vera based polymeric membrane optimization: Peel-off mask formulation for skin care cosmeceuticals in green nanotechnology. J. Mol. Struct. 2021, 1229, 129592. [Google Scholar] [CrossRef]
- Kartikeyan, A.; Vasudevan, V.; Peter, A.J.; Krishnan, N.; Velmurugan, D.; Velusamy, P.; Anbu, P.; Palani, P.; Raman, P. Effect of incubation period on the glycosylated protein content in germinated and ungerminated seeds of mung bean (Vigna radiata (L.) Wilczek). Int. J. Biol. Macromol. 2022, 217, 633–651. [Google Scholar] [CrossRef] [PubMed]
- Qiu, Y.; Yu, T.; Wang, W.; Pan, K.; Shi, D.; Sun, H. Curcumin-induced melanoma cell death is associated with mitochondrial permeability transition pore (mPTP) opening. Biochem. Biophys. Res. Commun. 2014, 448, 15–21. [Google Scholar] [CrossRef] [PubMed]
- Kanatt, S.R.; Arjun, K.; Sharma, A. Antioxidant and antimicrobial activity of legume hulls. Food Res. Int. 2011, 44, 3182–3187. [Google Scholar] [CrossRef]
- Bayan, M.F.; Marji, S.M.; Salem, M.S.; Begum, M.Y.; Chidambaram, K.; Chandrasekaran, B. Development of polymeric-based formulation as potential smart colonic drug delivery system. Polymers 2022, 14, 3697. [Google Scholar] [CrossRef]
- Obaidat, R.M.; Tashtoush, B.M.; Bayan, M.F.; TAl Bustami, R.; Alnaief, M. Drying using supercritical fluid technology as a potential method for preparation of chitosan aerogel microparticles. AAPS PharmSciTech 2015, 16, 1235–1244. [Google Scholar] [CrossRef]
- Ilango, K.B.; Gowthaman, S.; Seramaan, K.I.; Chidambaram, K.; Bayan, M.F.; Rahamathulla, M.; Balakumar, C. Mucilage of Coccinia grandis as an efficient natural polymer-based pharmaceutical excipient. Polymers 2022, 14, 215. [Google Scholar] [CrossRef]
- Heggset, E.B.; Strand, B.L.; Sundby, K.W.; Simon, S.; Chinga-Carrasco, G.; Syverud, K. Viscoelastic properties of nanocellulose based inks for 3D printing and mechanical properties of CNF/alginate biocomposite gels. Cellulose 2019, 26, 581–595. [Google Scholar] [CrossRef]
- Chen, Y.; Li, Z.; Chaves Figueiredo, S.; Çopuroğlu, O.; Veer, F.; Schlangen, E. Limestone and calcined clay-based sustainable cementitious materials for 3D concrete printing: A fundamental study of extrudability and early-age strength development. Appl. Sci. 2019, 9, 1809. [Google Scholar] [CrossRef]
- Supasatyankul, B.; Saisriyoot, M.; Klinkesorn, U.; Rattanaporn, K.; Sae-Tan, S. Extraction of phenolic and flavonoid compounds from mung bean (Vigna radiata) seed coat by pressurized liquid extraction. Molecules 2022, 27, 2085. [Google Scholar] [CrossRef]
- Kang, M.C.; Kim, S.Y.; Kim, Y.T.; Kim, E.A.; Lee, S.H.; Ko, S.C.; Wijesinghe, W.A.; Samarakoon, K.W.; Kim, Y.S.; Cho, J.H.; et al. In vitro and in vivo antioxidant activities of polysaccharide purified from aloe vera (Aloe barbadensis) gel. Carbohydr. Polym. 2014, 99, 365–371. [Google Scholar] [CrossRef] [PubMed]
- Al Aboody, M.S. Cytotoxic, antioxidant, and antimicrobial activities of Celery (Apium graveolens L.). Bioinformation 2021, 17, 147. [Google Scholar] [CrossRef] [PubMed]
- Bayan, M.F.; Salem, M.S.; Bayan, R.F. Development and in vitro evaluation of a large-intestinal drug delivery system. Res. J. Pharm. Technol. 2022, 15, 35–39. [Google Scholar] [CrossRef]
- Bayan, M.F.; Jaradat, A.; Alyami, M.H.; Naser, A.Y. Smart pellets for controlled delivery of 5-Fluorouracil. Molecules 2023, 28, 306. [Google Scholar] [CrossRef] [PubMed]
- Ourique, A.F.; Melero, A.; da Silva, C.D.; Schaefer, U.F.; Pohlmann, A.R.; Guterres, S.S.; Lehr, C.M.; Kostka, K.H.; Beck, R.C. Improved photostability and reduced skin permeation of tretinoin: Development of a semisolid nanomedicine. Eur. J. Pharm. Biopharm. 2011, 79, 95–101. [Google Scholar] [CrossRef]
- Shareen, R.; Kumar, S.; Gupta, G.D. Meloxicam carbopol-based gels: Characterization and evaluation. Curr. Drug Deliv. 2011, 8, 407–415. [Google Scholar] [CrossRef] [PubMed]
- Lu, Z.; Fassihi, R. Influence of colloidal silicon dioxide on gel strength, robustness, and adhesive properties of diclofenac gel formulation for topical application. AAPS PharmSciTech 2015, 16, 636–644. [Google Scholar] [CrossRef]

| Characteristics | Observation |
|---|---|
| Physical state | Semisolid |
| Color | Green |
| Odor | Characteristic |
| Taste | Characteristic |
| Constituents | Test | End Point | Results |
|---|---|---|---|
| Flavonoids | Ferric chloride | Green color | ++ |
| Lead acetate | Yellow precipitate | ++ | |
| Protein | Xanthoprotein | Yellow precipitate | ++ |
| Ninhydrin | Blue color | ++ | |
| Amino acids | Ninhydrin | Purple or bluish color | ++ |
| Tyrosine | Dark red color | ++ | |
| Phenol | Ferric chloride | Blue or red color | ++ |
| Organic acid | Phosphoric acid | Light yellow Precipitate | ++ |
| Sample | Staphylococcus aureus (ATTC-6538P) | Escherichia coli (ATCC-8739) | Candida albicans (ATCC-18804) |
|---|---|---|---|
| Inhibitory Zone (mm) | |||
| Polyherbal gel (F2) | 12.3 ± 0.1 | 13.2 ± 0.06 | 12.4 ± 0.1 |
| Gentamicin (10 mcg) | 22.2 ± 0.06 | 22.3 ± 0.1 | - |
| Fluconazole (25 mcg) | - | - | 22.2 ± 0.03 |
| Ingredients | G1 | G2 | G3 |
|---|---|---|---|
| Carbopol 940 | 1% | 1.5% | 2% |
| Propylene glycol | 5 mL | 5 mL | 5 mL |
| Methyl paraben | 0.15 g | 0.15 g | 0.15 g |
| Propyl paraben | 0.30 g | 0.30 g | 0.30 g |
| Triethanolamine | 5 mL | 5 mL | 5 mL |
| Water | q. s | q. s | q. s |
| Ingredients | F1 | F2 | F3 |
|---|---|---|---|
| Vigna radiata extract | 1% | 1.5% | 2% |
| Aloe barbadensis gel | 5 mL | 5 mL | 5 mL |
| Carbopol 940 | 2% | 2% | 2% |
| Propylene glycol | 5 mL | 5 mL | 5 mL |
| Methyl paraben | 0.15 g | 0.15 g | 0.15 g |
| Propyl paraben | 0.30 g | 0.30 g | 0.30 g |
| Triethanolamine | 5 mL | 5 mL | 5 mL |
| Water | q. s | q. s | q. s |
| Characteristics | F1 | F2 | F3 |
|---|---|---|---|
| Physical appearance | Transparent gel | Transparent gel | Transparent gel |
| Color | Pale yellow | Pale yellow | Pale yellow |
| Homogeneity | Absence of aggregates | Absence of aggregates | Slight aggregates |
| Formulation Code | pH | Viscosity (cps) | Spreadability (g cm/s) |
|---|---|---|---|
| F1 | 5.9 | 1428 ± 0.1 | 19.37 |
| F2 | 5.7 | 1425 ± 0.8 | 21.35 |
| F3 | 5.8 | 1358 ± 0.3 | 22.13 |
| Gel Strength/ m Value (g) Force 1 | Force at Target (cycle:1) (kg) | Radiant to Positive Peak (cycle:1) kg/s |
|---|---|---|
| 0.693 | 0.016 | 0.004 |
| Firmness (g) | Force at Target (Cycle:1) (kg) | Force at 5 mm (Cycle:1) (kg) |
|---|---|---|
| 3168.854 | 3.369 | 3.228 |
Disclaimer/Publisher’s Note: The statements, opinions and data contained in all publications are solely those of the individual author(s) and contributor(s) and not of MDPI and/or the editor(s). MDPI and/or the editor(s) disclaim responsibility for any injury to people or property resulting from any ideas, methods, instructions or products referred to in the content. |
© 2023 by the authors. Licensee MDPI, Basel, Switzerland. This article is an open access article distributed under the terms and conditions of the Creative Commons Attribution (CC BY) license (https://creativecommons.org/licenses/by/4.0/).
Share and Cite
Chellathurai, B.J.; Anburose, R.; Alyami, M.H.; Sellappan, M.; Bayan, M.F.; Chandrasekaran, B.; Chidambaram, K.; Rahamathulla, M. Development of a Polyherbal Topical Gel for the Treatment of Acne. Gels 2023, 9, 163. https://doi.org/10.3390/gels9020163
Chellathurai BJ, Anburose R, Alyami MH, Sellappan M, Bayan MF, Chandrasekaran B, Chidambaram K, Rahamathulla M. Development of a Polyherbal Topical Gel for the Treatment of Acne. Gels. 2023; 9(2):163. https://doi.org/10.3390/gels9020163
Chicago/Turabian StyleChellathurai, Benedict Jose, Ramyadevi Anburose, Mohammad H. Alyami, Mohan Sellappan, Mohammad F. Bayan, Balakumar Chandrasekaran, Kumarappan Chidambaram, and Mohamed Rahamathulla. 2023. "Development of a Polyherbal Topical Gel for the Treatment of Acne" Gels 9, no. 2: 163. https://doi.org/10.3390/gels9020163
APA StyleChellathurai, B. J., Anburose, R., Alyami, M. H., Sellappan, M., Bayan, M. F., Chandrasekaran, B., Chidambaram, K., & Rahamathulla, M. (2023). Development of a Polyherbal Topical Gel for the Treatment of Acne. Gels, 9(2), 163. https://doi.org/10.3390/gels9020163

